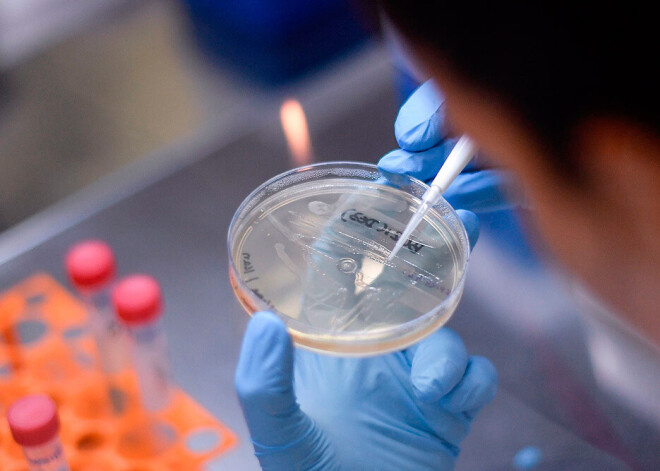

Lietuvā mājās mirušam vīrietim pēc nāves diagnosticē Covid-19
Lietuvā reģistrēts jau devītais nāves gadījums ar jaunā koronavīrusa izraisīto slimību Covid-19.
Nacionālā sabiedrības veselības dienesta Viļņas departamenta vadītāja Rolanda Liņģiene ziņu aģentūrai BNS ceturtdien pastāstīja, ka mirušais ir vīrietis, kurš dzīvojis Ukmerģē, kur bijuši jau vairāki Covid-19 izraisīti nāves gadījumi starp vietējās slimnīcas pacientiem.
Viņš miris mājās, un koronavīruss viņam diagnosticēts pēc nāves. Vīrietis, kurš bijis gados vecs, nav ārstējies slimnīcā, taču slimnīcā ārstējusies viņa radiniece, teica Liņģiene.
Jau ziņots, ka pirmais nāves gadījums ar Covid-19 Lietuvā reģistrēts 20.martā.
Pēc Veselības ministrijas ceturtdien publiskotajiem datiem, Lietuvā inficēšanās ar jauno koronavīrusu diagnosticēta jau kopumā 649 cilvēkiem.
Igaunijā ar Covid-19 līdz šim miruši 11 cilvēki, bet Latvijā nāves gadījumi nav bijuši.